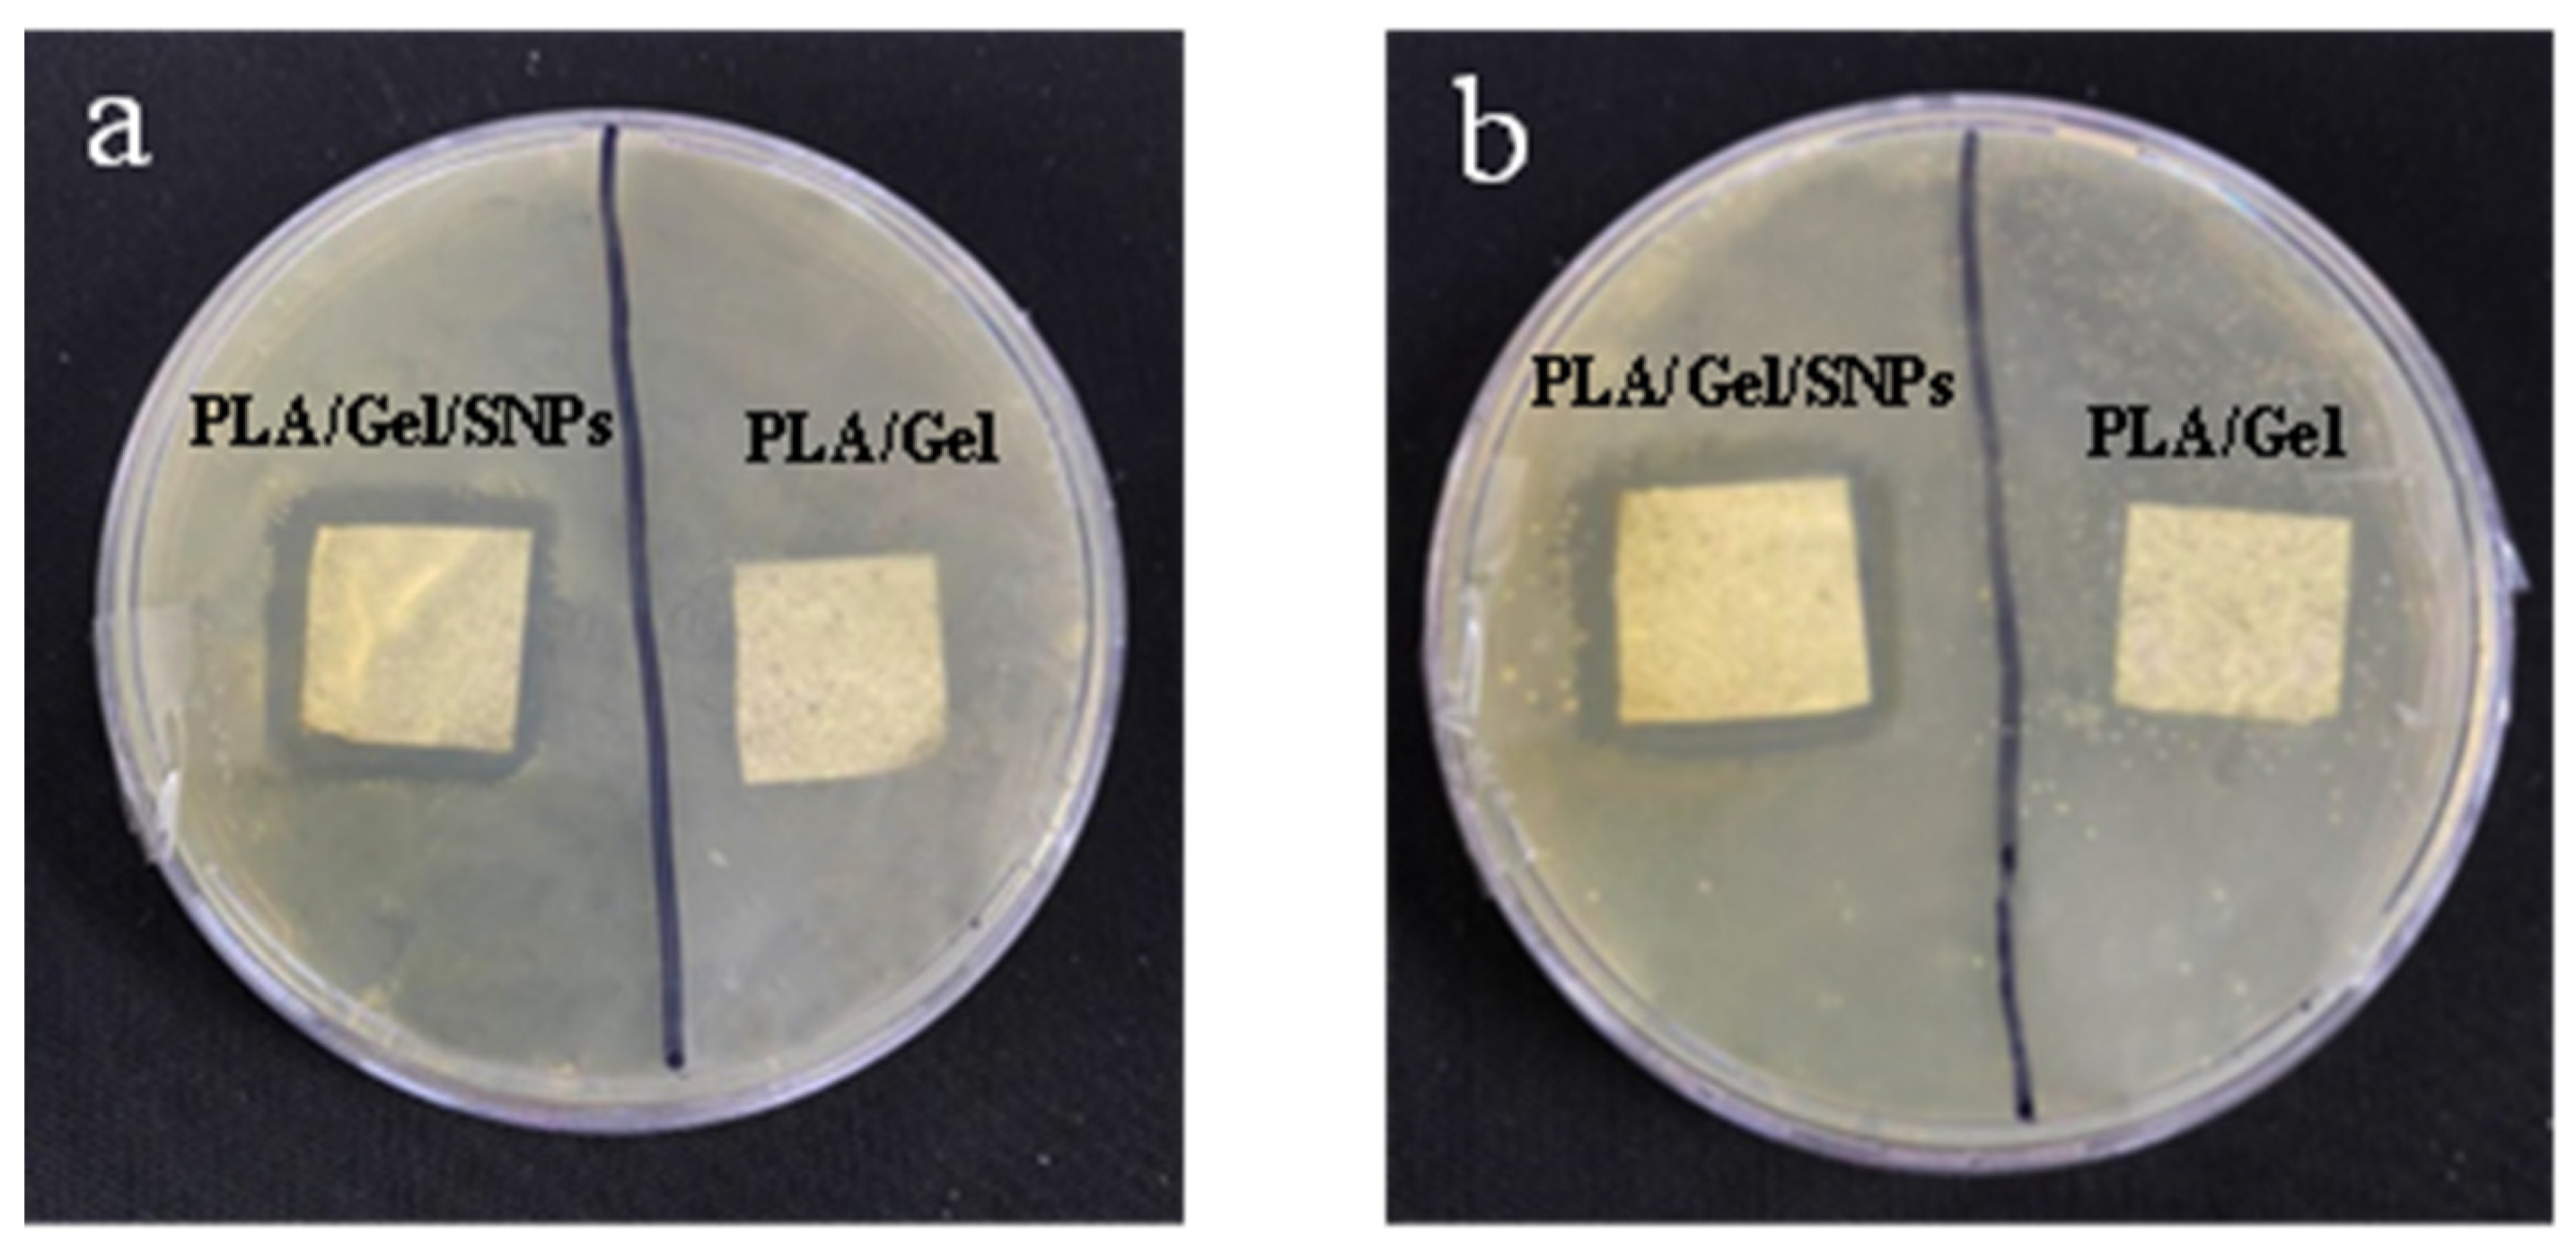
Bioengineering 09 00518 g008
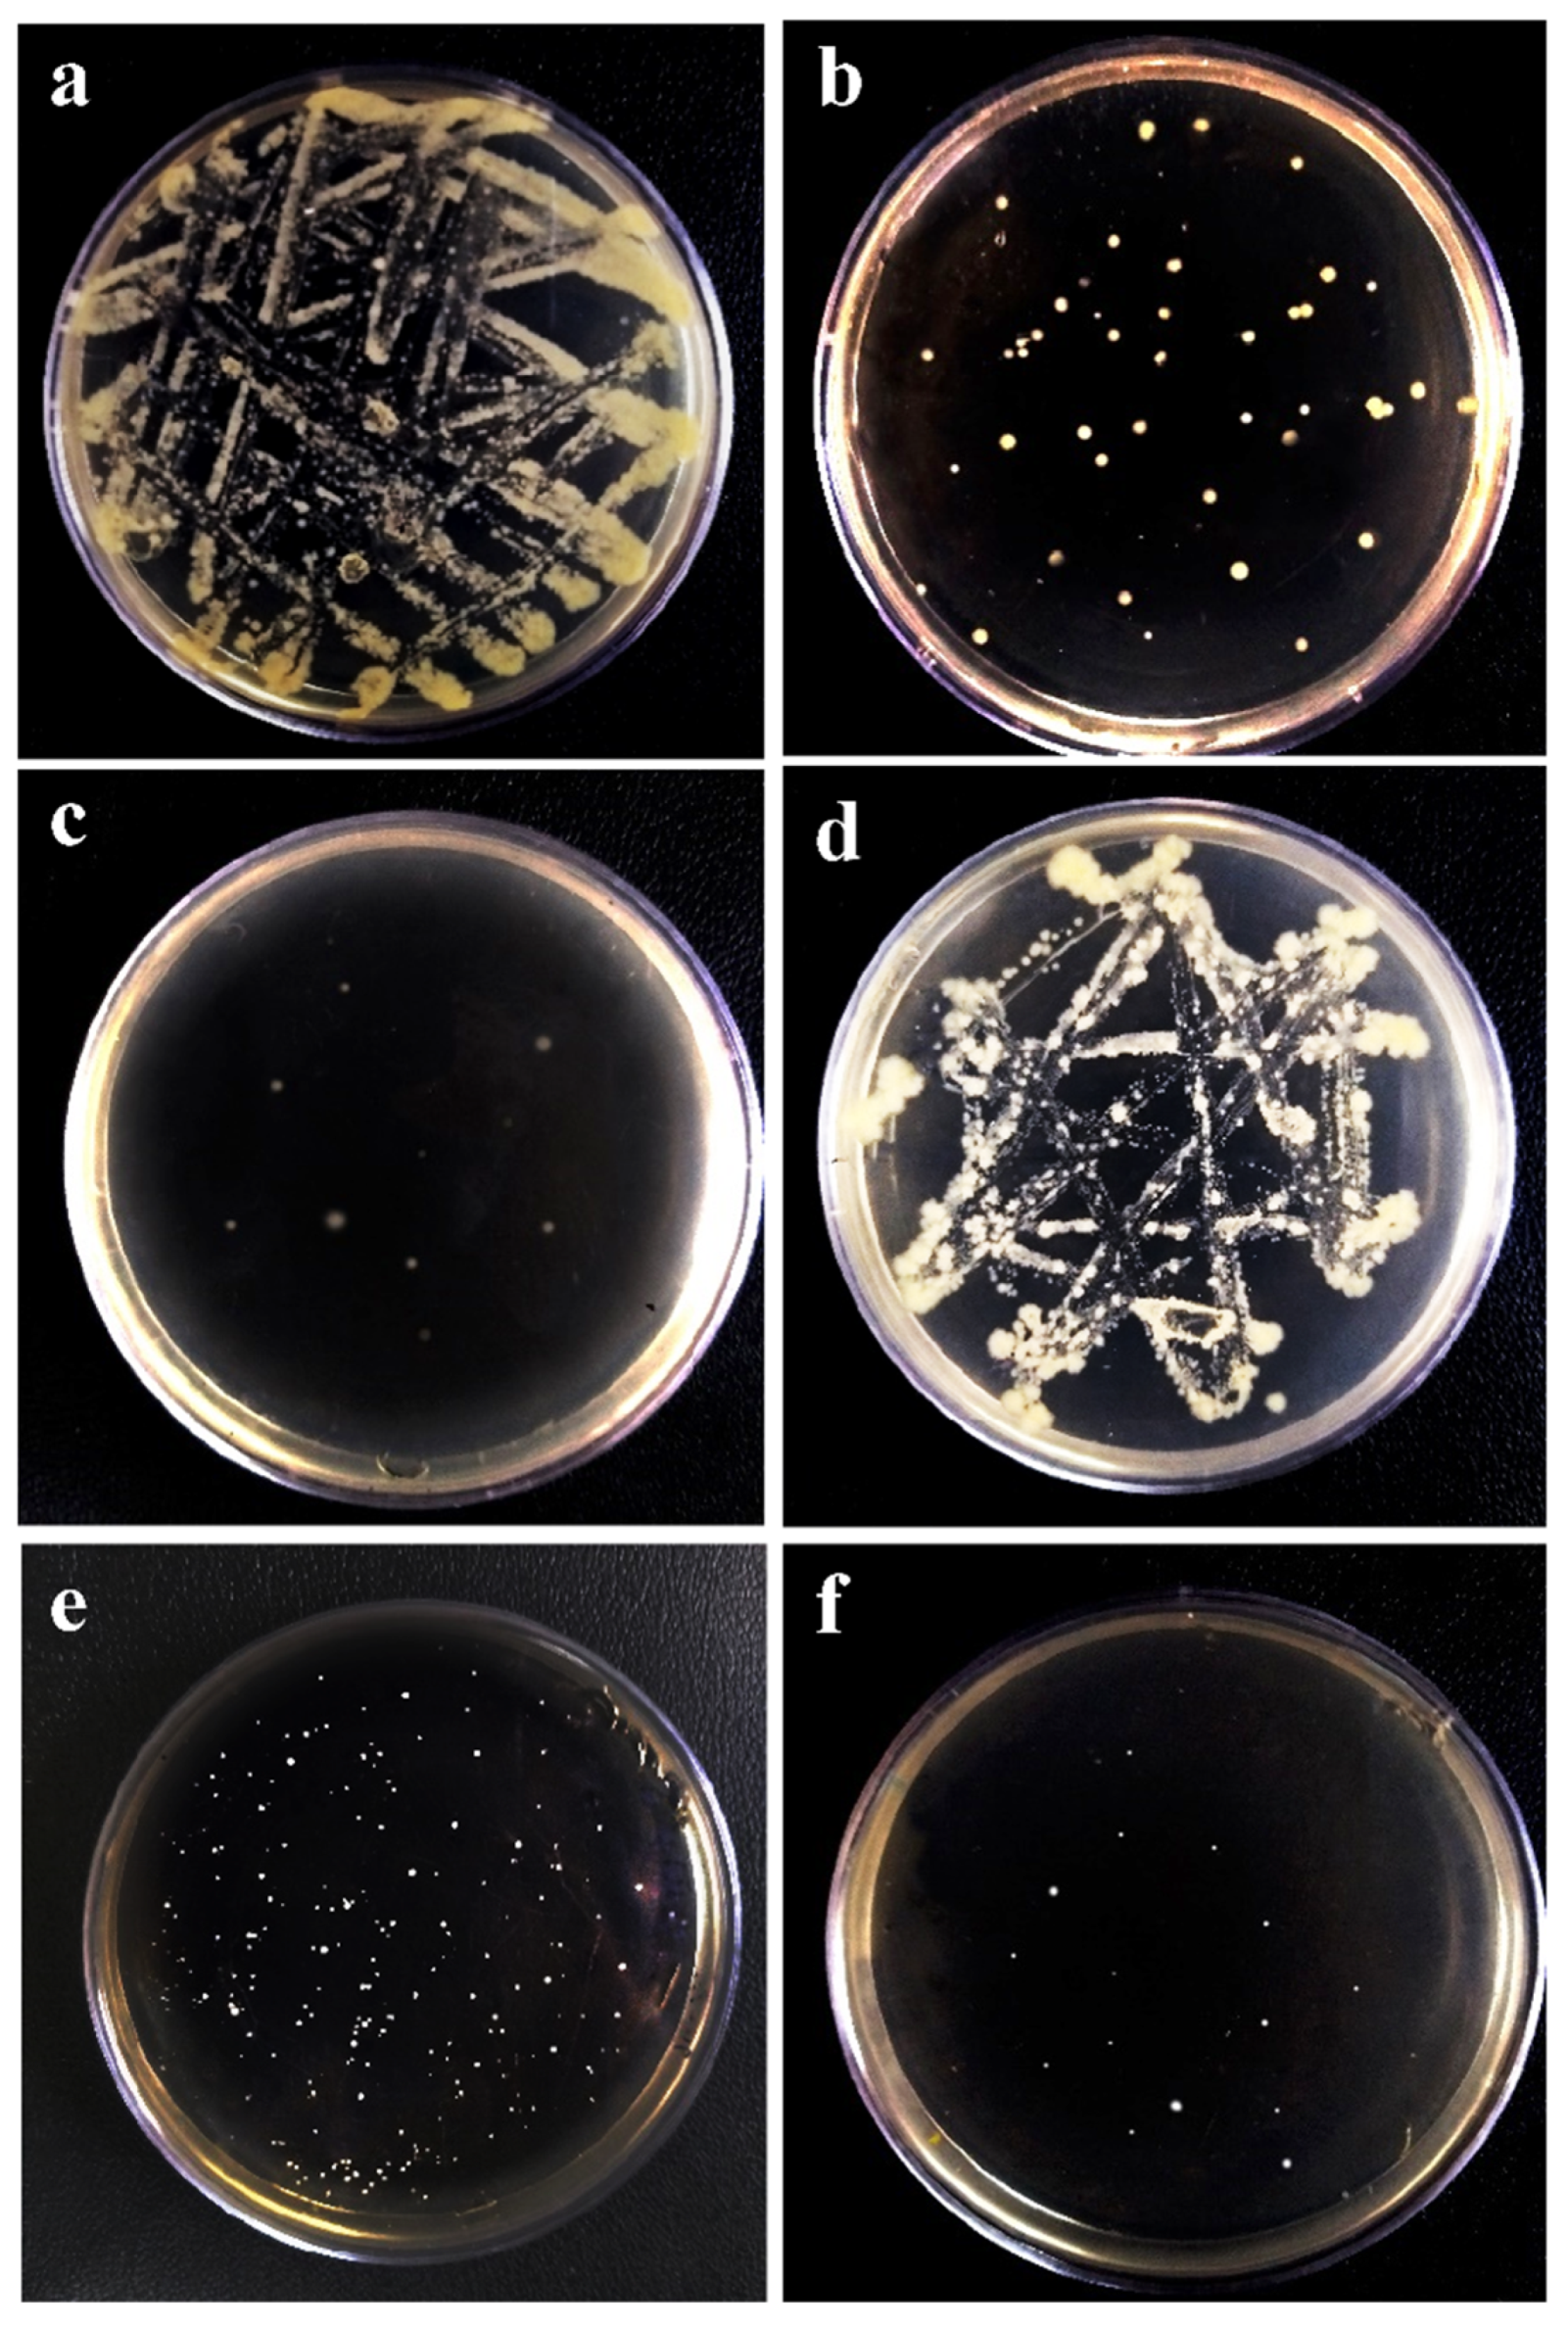
Bioengineering 09 00518 g010

Antimicrobial Activity of Blow Spun PLA/Gelatin Nanofibers Containing Green Synthesized Silver Nanoparticles against Wound Infection-Causing Bacteria
Abstract
1. Introduction
2. Materials and Methods
2.1. Green Synthesis of Silver Nanoparticles
2.2. Nanoparticle Characterization
2.3. Nanofiber Fabrication
2.4. SEM Analysis
2.5. Nanoparticle Release Measurement
2.6. Hemolysis Test
2.7. Cytotoxicity
2.8. Antibacterial Test
3. Results
3.1. Synthesis and Characterization of Silver Nanoparticles
3.2. Characterization of Nanofiber Mats
3.3. Blood Compatibility Test
3.4. Cytotoxicity Test
3.5. Antibacterial Activity
4. Discussions
5. Conclusions
Author Contributions
Funding
Institutional Review Board Statement
Informed Consent Statement
Data Availability Statement
Acknowledgments
Conflicts of Interest
References
- Bahadur, P.S.; Jaiswal, S.; Srivastava, R.; Kumar, A. Advanced application of nanotechnology in engineering. In Proceedings of the 2021 International Conference on Technological Advancements and Innovations (ICTAI), Tashkent, Uzbekistan, 10–12 November 2021; IEEE: New York, NY, USA, 2021; pp. 92–95. [Google Scholar]
- Talebian, S.; Rodrigues, T.; Neves, J.D.; Sarmento, B.; Langer, R.; Conde, J. Facts and figures on materials science and nanotechnology progress and investment. ACS Nano 2021, 15, 15940–15952. [Google Scholar] [CrossRef] [PubMed]
- Shah, A.S.; Surnar, B.; Kolishetti, N.; Dhar, S. Intersection of inorganic chemistry and nanotechnology for the creation of new cancer therapies. Accounts Mater. Res. 2022, 3, 283–296. [Google Scholar] [CrossRef]
- Kargozar, S.; Mozafari, M. Nanotechnology and nanomedicine: Start small, think big. Mater. Today: Proc. 2018, 5, 15492–15500. [Google Scholar] [CrossRef]
- Laouini, S.E.; Bouafia, A.; Soldatov, A.V.; Algarni, H.; Tedjani, M.L.; Ali, G.A.M.; Barhoum, A. Green synthesized of Ag/Ag2O nanoparticles using aqueous leaves extracts of Phoenix dactylifera L. and their azo dye photodegradation. Membranes 2021, 11, 468. [Google Scholar] [CrossRef]
- Noah, N.M. Design and synthesis of nanostructured materials for sensor applications. J. Nanomater. 2020, 2020, 8855321. [Google Scholar] [CrossRef]
- Pathakoti, K.; Manubolu, M.; Hwang, H.-M. Nanotechnology applications for environmental industry. In Handbook of Nanomaterials for Industrial Applications; Elsevier: Amsterdam, The Netherlands, 2018; pp. 894–907. [Google Scholar]
- Chen, X.; Cheng, L.; Li, H.; Barhoum, A.; Zhang, Y.; He, X.; Yang, W.; Bubakir, M.; Chen, H. Magnetic nanofibers: Unique properties, fabrication techniques, and emerging applications. ChemistrySelect 2018, 3, 9127–9143. [Google Scholar] [CrossRef]
- Zhang, X.; Li, L.; Ouyang, J.; Zhang, L.; Xue, J.; Zhang, H.; Tao, W. Electroactive electrospun nanofibers for tissue engineering. Nano Today 2021, 39, 101196. [Google Scholar] [CrossRef]
- Omer, S.; Forgách, L.; Zelkó, R.; Sebe, I. Scale-up of electrospinning: Market overview of products and devices for pharmaceutical and biomedical purposes. Pharmaceutics 2021, 13, 286. [Google Scholar] [CrossRef]
- Hu, J.; Wei, J.; Liu, W.; Chen, Y. Preparation and characterization of electrospun PLGA/gelatin nanofibers as a drug delivery system by emulsion electrospinning. J. Biomater. Sci. Polym. Ed. 2013, 24, 972–985. [Google Scholar] [CrossRef]
- Mercante, L.; Pavinatto, A.; Pereira, T.; Migliorini, F.; Martins, D.; Correa, D. Nanofibers interfaces for biosensing: Design and applications. Sensors Actuators Rep. 2021, 3, 100048. [Google Scholar] [CrossRef]
- Alven, S.; Buyana, B.; Feketshane, Z.; Aderibigbe, B.A. Electrospun nanofibers/nanofibrous scaffolds loaded with silver nanoparticles as effective antibacterial wound dressing materials. Pharmaceutics 2021, 13, 964. [Google Scholar] [CrossRef] [PubMed]
- Dilamian, M.; Joghataei, M.; Ashrafi, Z.; Bohr, C.; Mathur, S.; Maleki, H. From 1D electrospun nanofibers to advanced multifunctional fibrous 3D aerogels. Appl. Mater. Today 2021, 22, 100964. [Google Scholar] [CrossRef]
- Zhang, X.; Qin, M.; Xu, M.; Miao, F.; Merzougui, C.; Zhang, X.; Wei, Y.; Chen, W.; Huang, D. The fabrication of antibacterial hydrogels for wound healing. Eur. Polym. J. 2021, 146, 110268. [Google Scholar] [CrossRef]
- Yuan, Z.; Cheng, J.; Lan, G. A cellulose/Konjac glucomannan–based macroporous antibacterial wound dressing with synergistic and complementary effects for accelerated wound healing. Cellulose 2021, 28, 5591–5609. [Google Scholar] [CrossRef]
- Farazin, A.; Torkpour, Z.; Dehghani, S.; Mohammadi, R.; Fahmy, M.; Saber-Samandari, S.; Labib, K.; Khandan, A. A review of polymeric wound dress for the treatment of burns and diabetic wounds. Int. J. Basic Sci. Med. 2021, 6, 44–50. [Google Scholar] [CrossRef]
- Rippon, M.G.; Mikosiński, J.; Rogers, A.A. HydroTac-a hydro-responsive wound dressing: A review of the in vitro evidence. J. Wound Care 2022, 31, 540–547. [Google Scholar] [CrossRef]
- Bal-Öztürk, A.; Özkahraman, B.; Özbaş, Z.; Yaşayan, G.; Tamahkar, E.; Alarçin, E. Advancements and future directions in the antibacterial wound dressings—A review. J. Biomed. Mater. Res. Part B Appl. Biomater. 2021, 109, 703–716. [Google Scholar] [CrossRef]
- Nath, D.; Banerjee, P.; Ray, A.; Bairagi, B. Green peptide–nanomaterials; A friendly healing touch for skin wound regeneration. Adv. Nano Res. 2019, 2, 14–31. [Google Scholar] [CrossRef]
- Romano, I.; Summa, M.; Heredia-Guerrero, J.; Spanò, R.; Ceseracciu, L.; Pignatelli, C.; Bertorelli, R.; Mele, E.; Athanassiou, A. Fumarate-loaded electrospun nanofibers with anti-inflammatory activity for fast recovery of mild skin burns. Biomed. Mater. 2016, 11, 041001. [Google Scholar] [CrossRef]
- Squinca, P.; Berglund, L.; Hanna, K.; Rakar, J.; Junker, J.; Khalaf, H.; Farinas, C.S.; Oksman, K. Multifunctional ginger nanofiber hydrogels with tunable absorption: The potential for advanced wound dressing applications. Biomacromolecules 2021, 22, 3202–3215. [Google Scholar] [CrossRef]
- Song, J.; Kim, M.; Lee, H. Recent advances on nanofiber fabrications: Unconventional state-of-the-art spinning techniques. Polymers 2020, 12, 1386. [Google Scholar] [CrossRef] [PubMed]
- Bhagwan, J.; Kumar, N.; Sharma, Y. Fabrication, characterization, and optimization of MnxOy nanofibers for improved supercapacitive properties. In Nanomaterials Synthesis; Elsevier: Amsterdam, The Netherlands, 2019; pp. 451–481. [Google Scholar]
- Medeiros, E.; Glenn, G.; Klamczynski, A.; Orts, W.J.; Mattoso, L. Solution blow spinning: A new method to produce micro- and nanofibers from polymer solutions. J. Appl. Polym. Sci. 2009, 113, 2322–2330. [Google Scholar] [CrossRef]
- Jia, C.; Li, L.; Song, J.; Li, Z.; Wu, H. Mass production of ultrafine fibers by a versatile solution blow spinning method. Accounts Mater. Res. 2021, 2, 432–446. [Google Scholar] [CrossRef]
- Mihai, M.M.; Dima, M.B.; Dima, B.; Holban, A.M. Nanomaterials for wound healing and infection control. Materials 2019, 12, 2176. [Google Scholar] [CrossRef] [PubMed]
- Avcu, E.; Bastan, F.E.; Guney, M.; Avcu, Y.Y.; Rehman, M.A.U.; Boccaccini, A.R. Biodegradable polymer matrix composites containing graphene-related materials for antibacterial applications: A critical review. In Acta Biomaterialia; Elsevier: Amsterdam, The Netherlands, 2022; pp. 451–481. [Google Scholar]
- Sandri, G.; Miele, D.; Faccendini, A.; Bonferoni, M.C.; Rossi, S.; Grisoli, P.; Taglietti, A.; Ruggeri, M.; Bruni, G.; Vigani, B.; et al. Chitosan/glycosaminoglycan scaffolds: The role of silver nanoparticles to control microbial infections in wound healing. Polymers 2019, 11, 1207. [Google Scholar] [CrossRef] [PubMed]
- Mani, M.; Jaganathan, S. Physicochemical and blood compatibility characteristics of garlic incorporated polyurethane nanofibrous scaffold for wound dressing applications. J. Text. Inst. 2019, 110, 1615–1623. [Google Scholar] [CrossRef]
- Sadeghianmaryan, A.; Yazdanpanah, Z.; Soltani, Y.; Sardroud, H.; Nasirtabrizi, M.; Chen, X. Curcumin-loaded electrospun polycaprolactone/montmorillonite nanocomposite: Wound dressing application with anti-bacterial and low cell toxicity properties. J. Biomater. Sci. Polym. Ed. 2020, 31, 169–187. [Google Scholar] [CrossRef]
- Babu, A.; Saravanakumar, S.S.; Balaji, S. Influence of silver nanoparticles on mechanical, thermal and antibacterial properties of poly (vinyl alcohol)/rice hull powder hybrid biocomposite films. Polym. Compos. 2022, 43, 2824–2837. [Google Scholar] [CrossRef]
- Mousavi-Khattat, M.; Nourbakhshan, H.; Afrazeh, S.; Aminorroaya, S.H.; Shakeran, Z. Donkey dung–mediated synthesis of silver nanoparticles and evaluation of their antibacterial, antifungal, anticancer, and DNA cleavage activities. BioNanoScience 2022, 12, 877–889. [Google Scholar] [CrossRef]
- Lu, Z.; Xiao, J.; Wang, Y.; Meng, M. In situ synthesis of silver nanoparticles uniformly distributed on polydopamine-coated silk fibers for antibacterial application. J. Colloid Interface Sci. 2015, 452, 8–14. [Google Scholar] [CrossRef]
- Dash, S.; Murthy, P.; Nath, L.; Chowdhury, P. Kinetic modeling on drug release from controlled drug delivery systems. Acta Pol. Pharm. 2010, 67, 217–223. [Google Scholar] [PubMed]
- Safaee-Ardakani, M.R.; Hatamian-Zarmi, A.; Sadat, S.M.; Mokhtari-Hosseini, Z.B.; Ebrahimi-Hosseinzadeh, B.; Kooshki, H.; Rashidiani, J. In situ preparation of PVA/schizophyllan-AgNPs nanofiber as potential of wound healing: Characterization and cytotoxicity. Fibers Polym. 2019, 20, 2493–2502. [Google Scholar] [CrossRef]
- Pinho, E.; Magalhães, L.; Henriques, M.; Oliveira, R. Antimicrobial activity assessment of textiles: Standard methods comparison. Ann. Microbiol. 2010, 61, 493–498. [Google Scholar] [CrossRef]
- Qiao, H.; Song, G.; Huang, Y.; Yang, H.; Han, S.; Zhang, X.; Wang, Z.; Ma, J.; Bu, X.; Fu, L. Si, Sr, Ag co-doped hydroxyapatite/TiO2 coating: Enhancement of its antibacterial activity and osteoinductivity. RSC Adv. 2019, 9, 13348–13364. [Google Scholar] [CrossRef] [PubMed]
- Jebril, S.; Jenana, R.K.B.; Dridi, C. Green synthesis of silver nanoparticles using Melia azedarach leaf extract and their antifungal activities: In vitro and in vivo. Mater. Chem. Phys. 2020, 248, 122898. [Google Scholar] [CrossRef]
- Kwak, H.W.; Kim, J.E.; Lee, K.H. Green fabrication of antibacterial gelatin fiber for biomedical application. React. Funct. Polym. 2019, 136, 86–94. [Google Scholar] [CrossRef]
- İnal, M.; Mülazımoğlu, G. Production and characterization of bactericidal wound dressing material based on gelatin nanofiber. Int. J. Biol. Macromol. 2019, 137, 392–404. [Google Scholar] [CrossRef]
- Cui, S.; Sun, X.; Li, K.; Gou, D.; Zhou, Y.; Hu, J.; Liu, Y. Polylactide nanofibers delivering doxycycline for chronic wound treatment. Mater. Sci. Eng. C 2019, 104, 109745. [Google Scholar] [CrossRef]
- Khattat, S.M.M.; Keyhanfar, M.; Razmjou, A. A comparative study of stability, antioxidant, DNA cleavage and antibacterial activities of green and chemically synthesized silver nanoparticles. Artif. Cells, Nanomed. Biotechnol. 2018, 46, S1022–S1031. [Google Scholar] [CrossRef]
- Gulsun, T.; Inal, M.; Akdag, Y.; Izat, N.; Oner, L.; Sahin, S. The development and characterization of electrospun gelatin nanofibers containing indomethacin and curcumin for accelerated wound healing. J. Drug Deliv. Sci. Technol. 2021, 67, 103000. [Google Scholar] [CrossRef]
- Jun, I.; Han, H.-S.; Edwards, J.; Jeon, H. Electrospun fibrous scaffolds for tissue engineering: Viewpoints on architecture and fabrication. Int. J. Mol. Sci. 2018, 19, 745. [Google Scholar] [CrossRef] [PubMed]
- Laracuente, M.-L.; Yu, M.H.; McHugh, K.J. Zero-order drug delivery: State of the art and future prospects. J. Control. Release 2020, 327, 834–856. [Google Scholar] [CrossRef]
- de Souza, T.A.J.; Souza, L.R.R.; Franchi, L.P. Silver nanoparticles: An integrated view of green synthesis methods, transformation in the environment, and toxicity. Ecotoxicol. Environ. Saf. 2019, 171, 691–700. [Google Scholar] [CrossRef] [PubMed]
- Leyva-Verduzco, A.A.; Castillo-Ortega, M.M.; Chan-Chan, L.H.; Silva-Campa, E.; Galaz-Méndez, R.; Vera-Graziano, R.; Encinas-Encinas, J.C.; del Castillo-Castro, T.; Rodríguez-Félix, D.E.; Santacruz-Ortega, H.D.C.; et al. Electrospun tubes based on PLA, gelatin and genipin in different arrangements for blood vessel tissue engineering. Polym. Bull. 2020, 77, 5985–6003. [Google Scholar] [CrossRef]
- Karayıldırım, Ç.K.; Nalbantsoy, A.; Yavaşoğlu, N. Cytotoxicity and genotoxicity of butyl cyclohexyl phthalate. Cytotechnology 2014, 68, 213–222. [Google Scholar]
- Shetty, K.; Bhandari, A.; Yadav, K.S. Nanoparticles incorporated in nanofibers using electrospinning: A novel nano-in-nano delivery system. J. Control. Release 2022, 350, 421–434. [Google Scholar] [CrossRef]
- Sadri, M.; Arab-Sorkhi, S.; Vatani, H.; Bagheri-Pebdeni, A. New wound dressing polymeric nanofiber containing green tea extract prepared by electrospinning method. Fibers Polym. 2015, 16, 1742–1750. [Google Scholar] [CrossRef]
- Hosseini, H.; Shahraky, M.; Amani, A.; Landi, F.S. Electrospinning of polyvinyl alcohol/chitosan/hyaluronic acid nanofiber containing growth hormone and its release investigations. Polym. Adv. Technol. 2020, 32, 574–581. [Google Scholar] [CrossRef]
- Liao, C.; Li, Y.; Tjong, S.C. Antibacterial activities of aliphatic polyester nanocomposites with silver nanoparticles and/or graphene oxide sheets. Nanomaterials 2019, 9, 1102. [Google Scholar] [CrossRef]

| Formulation/Model | Kors-Peppas | Zero Order | First Order | Higuchi | Hixson |
|---|---|---|---|---|---|
| PLA.NPs | R² = 0.8987 | R² = 0.996 | R² = 0.9913 | R² = 0.9401 | R² = 0.995 |
| Gel.NPs | R² = 0.9165 | R² = 0.9946 | R² = 0.9637 | R² = 0.9402 | R² = 0.9856 |
| PLA.Gel.NPs | R² = 0.9027 | R² = 0.9965 | R² = 0.9705 | R² = 0.9307 | R² = 0.9861 |
Publisher’s Note: MDPI stays neutral with regard to jurisdictional claims in published maps and institutional affiliations. |
© 2022 by the authors. Licensee MDPI, Basel, Switzerland. This article is an open access article distributed under the terms and conditions of the Creative Commons Attribution (CC BY) license (https://creativecommons.org/licenses/by/4.0/).
Share and Cite
Alinezhad Sardareh, E.; Shahzeidi, M.; Salmanifard Ardestani, M.T.; Mousavi-Khattat, M.; Zarepour, A.; Zarrabi, A. Antimicrobial Activity of Blow Spun PLA/Gelatin Nanofibers Containing Green Synthesized Silver Nanoparticles against Wound Infection-Causing Bacteria. Bioengineering 2022, 9, 518. https://doi.org/10.3390/bioengineering9100518
Alinezhad Sardareh E, Shahzeidi M, Salmanifard Ardestani MT, Mousavi-Khattat M, Zarepour A, Zarrabi A. Antimicrobial Activity of Blow Spun PLA/Gelatin Nanofibers Containing Green Synthesized Silver Nanoparticles against Wound Infection-Causing Bacteria. Bioengineering. 2022; 9(10):518. https://doi.org/10.3390/bioengineering9100518
Chicago/Turabian StyleAlinezhad Sardareh, Elham, Moloud Shahzeidi, Mohammad Taha Salmanifard Ardestani, Mohammad Mousavi-Khattat, Atefeh Zarepour, and Ali Zarrabi. 2022. "Antimicrobial Activity of Blow Spun PLA/Gelatin Nanofibers Containing Green Synthesized Silver Nanoparticles against Wound Infection-Causing Bacteria" Bioengineering 9, no. 10: 518. https://doi.org/10.3390/bioengineering9100518
APA StyleAlinezhad Sardareh, E., Shahzeidi, M., Salmanifard Ardestani, M. T., Mousavi-Khattat, M., Zarepour, A., & Zarrabi, A. (2022). Antimicrobial Activity of Blow Spun PLA/Gelatin Nanofibers Containing Green Synthesized Silver Nanoparticles against Wound Infection-Causing Bacteria. Bioengineering, 9(10), 518. https://doi.org/10.3390/bioengineering9100518

